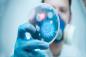

週間ランキング
- 期間:2015/01/05~01/11 カテゴリー総合
-
宇宙からのお年玉キター!1月7日、緑色の彗星「ラブジョイ」が地球に最大接近!肉眼でも観測可能に。次のチャンスは8000年後
- 3883 points
-
ほとんど元に戻ったよ。世界的に有名となった緑色の猫、動物愛好家の手によって無事捕獲、洗浄作業が行われる。
- 3128 points
-
なるほどわからん。頭がカオス化する、気の遠くなるような10のパラドックス(論理的矛盾)の世界
- 1603 points
-
ヴァイキングの超絶無敵の剣、「ウルフバート」の謎に迫る。伝説の鍛冶職人はドイツの修道士の可能性。
- 1445 points
-
がっかりだよ。CIAが今頃になって、1950~60年代に目撃されたUFOの半数はCIAのものであることを暴露
- 1373 points
-
地球上でもっとも汚染された25の場所
- 1065 points
-
事実はフィクションよりもすごかった。実在する9人の凄腕スナイパーたちとそのサイドストーリー
- 1002 points
-
抱かれたい、抱きしめたい。スキンシップで心を通わせる犬と人間のあったかい写真
- 786 points
-
どうあがいても自然にはかなわない。ファインアートよりもファインアートな世界15の湖の氷のオブジェ
- 759 points
-
引きこもりたい時に引きこもれる。自分だけの秘密基地 「ポケットに入る家」
- 693 points
-
マウスよりもイタチでしょ!マウスを動かす手にじゃれつきまくるイタチ
- 692 points
-
とにかく鼻を温めるんだ!寒い冬の風邪予防には鼻を温めるのが効果的(米研究)
- 681 points
-
断末魔の叫び声が聞こえる。アステカ族の死のホイッスル(音声注意)
- 554 points
-
古典的で未来的、攻殻機動隊などのイラストを手掛けるキリアン・イングのSFコミックアートの世界
- 554 points
-
もしも月と同じ距離に太陽系惑星があったら地球からどう見える?4K夜バージョン
- 535 points
-
プーチンの下で働けるチャンス到来!ロシアで外国人傭兵を雇う提案に対し署名
- 524 points
-
海外でも以外と多かった。食品の異物混入15のケース(閲覧注意)
- 503 points
-
目からうろこのライフハック。自動車の給油口がどちら側にあるのか車内から簡単にわかる方法
- 458 points
-
ポーランドの写真家が表現する希望と不安が交差するパラレルワールドの世界
- 365 points
-
猫2匹と結婚した女性。今年結婚10周年を迎えとても幸せ。人間の男は必要ないわ。(スペイン)
- 297 points
-
本当の笑顔と作り笑いの見分け方
- 288 points
-
ただ流されるままプカプカ漂う、そんなクラゲに私はなりたい。毒とか触手とかもついてるし。神秘的で繊細なるクラゲたちの画像特集
- 269 points
-
プーチンの養分たちはこんなに楽しそうだ!ロシアの警察部隊がファレル・ウィリアムスの「ハッピー」を完全カバーしたPVが公開される
- 266 points
-
こりゃたまらんらん!!見ている方のコリもほぐれるマッサージされて至福の表情を浮かべる猫
- 263 points
-
ジャンクフードにも免疫が?4人に1人はファストフードを食べ続けても健康状態が維持できることが判明(米研究)
- 256 points
-
科学的根拠にもとづく、月曜日が最悪の気分になる6つの理由
- 236 points
-
もうひとつの世界へのポータル?伝説の島「ハイブラジル」は異次元へのポータルなのか?
- 217 points
-
グーグル検索、YAHOO知恵袋がなかったあの時代、ニューヨークの公立図書館に寄せられた15の珍質問
- 213 points
-
2015年度に登場するかもしれない5つの最新技術。
- 197 points
-
「今テレビ見てるからー!」、集中してテレビを見入っている猫、あっちいっての催促目線
- 193 points
-
兵士たちの束の間の休息。リラックスする兵士たちの画像
- 191 points
-
ていっ! かわいいけど戦っちゃう。戦う動物たちの動画10連発
- 190 points
-
ひとなつこいゾウアザラシが撫でてほしそうにお姉さんの膝にすり寄ってきた!
- 186 points
-
なぜ人は「7」 という数字が好きなのか?
- 181 points
-
正直まだ寝ていたい。ピンクの布団をかぶり頭をなでられながらベッドでうとうとしてたい。そう、このハムスターみたいに。
- 177 points
-
なぜ物忘れをするのか? 記憶に関する5つの不思議な事実
- 168 points
-
ストップモーション・アニメーションの動きはこのように作られていた。映画「ボックストロール」の舞台裏
- 158 points
-
ウサギ団子の季節がやってきました。寄り集まって丸くなって寒さしのぐウサギたち
- 158 points
-
これもある意味縁起物?羊の皮を被った柴犬現る!?
- 154 points
-
医薬開発に革命が起きるか?抗生物質開発の新手法「ゲーム・チェンジャー」とは?
- 146 points
-
Google ストリートビューがとらえた珍光景20
- 144 points
-
吉報か?凶報か?住民たちを畏怖の念を抱かせた、竜の巣のようなアーチ雲(ブラジル)
- 136 points
-
サイバーなリスの個体が確認されただと?宇宙リスが裏庭にいるし!!
- 124 points
-
芸術の価値とは?2014年最優秀アートに選ばれた10の近代的芸術作品(一部虫混入注意)
- 121 points
-
新年を祝う花火の中に現れた緑色に光る円盤型のUFO?(英ロンドン)
- 90 points
-
思わず見入ってしまう。アクリル絵の具が織りなすサイケデリックな有機的フォルムを撮影したアート作品「Bruce」
- 89 points
-
切断された人間の指?オーストラリアの浜辺で発見された物騒な謎生物に警察も困惑状態
- 86 points
-
トラの跳躍力が凄かった。本気だせば柵とか余裕で越えられるな
- 80 points
-
嫌な予感しかしない。子供向けテレビ番組のスタジオで火を噴く曲芸大失敗
- 61 points
582/950